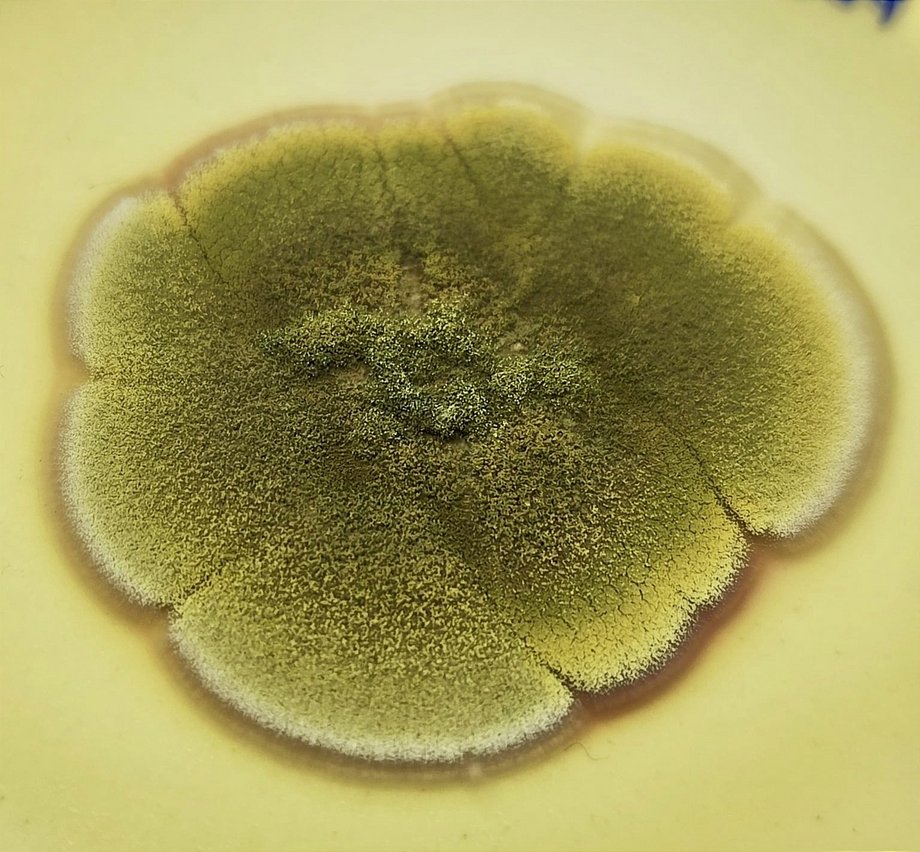

Aktuelle Projekt
Der Lehrstuhl Biotechnologie der Wasseraufbereitung befasst sich mit der Entwicklung von Methoden und Verfahren bspw. für die Reinigung industrieller Abwässer, der Elimination von hoch persistenten Substanzen aus Abwasser mit oxidativen Verfahren wie UV- und O3-Behandlungen von persistenten Substanzgruppen (PFAS, Phosphonate) sowie der Entfernung von Spurenverunreinigungen (Pharmaka, endokrine Wirkstoffe) aus Abwässern.
Desweiteren entwickelt der Lehrstuhl innovative Desinfektionsmethoden basierend auf Nanosilber eingebettet in porösem Glas (MacroSpec). Die Reduktion von Biofouling in Membranbioreaktoren mithilfe von Quorum Quenching sowie die solare Trinkwasserdeinfektion mit kombinierter APO sind weitere Forschungsschwerpunkte des Lehrstuhl. Die Ermittlung des Gefährungspotentials durch flüchtige Arsenverbindungen ausgehend von Pigmenten in historischen Objekten (Schweifurter Grün) rundet die Forschungsvielfalt des Lehrstuhls ab. Mehr Details zu unseren jeweiligen Forschungsschwerpunkten finden auf dieser Seite weiter unten.
Bei Interesse an einer Abschlussarbeit (Bachelor oder Master), oder an einem Studienprojekt, oder Praxissemster sprechen Sie uns bitte direkt an. In den unten aufgeführten Projekten gibt es regelmäßig die Möglichkeit für unsere Studierenden Abschlussarbeiten oder sonstiges anzufertigen.
Innovative Desinfektion mit Nanosilber in porösem Glas
Im aktuellen ZIM Projekt MakroSpec werden verschiedene mit Silber dotierte poröse Glasmaterialien auf ihre desinfizierende Wirkung untersucht, die entweder auf einer Kontaktdesifektion oder auf der Abgabe von geringen Silbermengen ins umgebende Medium beruhen. Ziel ist die Entwicklung einer Anwendungstechnologie zur Desinfektion von Wasser in Kühlkreisläufen oder anderen Industriellen Anwendungen, der Entkeimung von Poolwasser oder von Wasser für Sprühnebel, der für Kühlzwecke in mediteranen Gebieten eingesetzt wird. Mögliche Vorteile bestehen in der Einsparung von umweltgefährdenden bzw. gesundheitlich relevanten Chemikalien und der Ersatz durch ein chemikalienfreies System, welches wartungsarm ist und wesentlich längere Standzeiten als üblich erlaubt. Das zu entwickelnde Produkt beruht auf ersten Laborversuchen zur festen Immobilisierung von Silber und ggf. Kupfer an porösen Gläsern, sowie auf einem von der Firma FEW entwickelten Sinterverfahren, welches für die hier geplante Produktentwicklung genutzt und weiterentwickelt werden soll.
Weitere Entwicklungs- und Anwendungspoteniale liegen in der Immobilisierung von Titandioxid in der Glasmatrix und dem anschließenden Einsatz als Katalysator in einem sogenannten "Advanced Oxidization Process" (engl. AOP) als alternative Methode zur Desinfektion, sowie der Entfernung von schwer Abbaubaren Spurenstoffen wie Pharmazeutika oder halogener Verbindungen wie fluor-organischer Stoffe.
Interessierte Studierende, die eine Studienarbeit, Bachelorarbeit und/oder Masterarbeit in diesem Forschungsprojekt anfertigen wollen, kontaktieren bitte unsere Ansprechpartner*innen. Wir freuen uns auch über Anfragen von Studierenden, die ein Forschungs- und/oder Praxissemester bei uns am Lehrstuhl absolvieren wollen. Auch Praktia oder wissenschaftliche Gastaufenthalte sind an unserem Lehrstuhl herzlich willkommen. Bei nährerem Interesse nehmen Sie bitte direkt Kontakt mit uns auf:
Ansprechpartner*innen: Dr. Jörg Böllman & Prof. Dr. Marion Martienssen
Photochemischer, photokatalytischer und biologischer Abbau von Phosphonaten
Der Lehrstuhl beschäftigt sich seit vielen Jahren mit dem abiotischen und biologischen Abbau von Phosphonaten wie ATMP, EDTMP, DTPMP und HEDP. Ziel der Untersuchungen ist es das Umweltverhalten dieser stabilien Komplexbildner aufzuklären und Prognosen über deren Verbleib in der Umwelt herzuleiten. Die Frage der potentiellen Verweilzeit und mögliche Abbaupfade spielen dabei eine übergeorndete Rolle. Für Letzteres wurde bisher stets angenommen, dass vor allem abiotische Abbaumechanismen eine primäre Rolle spielen. In diesem Zusammenhang untersucht der Lehrstuhl intensiv den photochemischen sowie nano-photokatalytischen Abbau von bekannten Aminophosphonaten und deren Abbau mittels LC/MS-Messungen. Die Freisetzung von weiteren Zwischenprodukten wird ebenfalls mittels LC/MS-Messungen erfasst. Die Übertragbarkeit der aufgeklärten Abbaumechanismen auf Sonnenlicht konnte bereits für die Struktur DTPMP belegt werden.
Neben den photochemischen Untersuchungen forscht der Lehrstuhl intensiv am biologischen Abbau von diversen Aminophosphonatstrukturen. Der Lejrstuhl hat eigens dafür ein neues standardisiertes Testverfahren entwickelt mit dem es nun möglich ist Reinkulturen wie auch gezielte Mischkulturen, oder Abwasserschlämme und Biofilme gezielt hinsichtlich der biologischen Abbaubarkeit dieser Strukturen hin zu untersuchen. So werden aktuell acht verschiedene Umweltstämme aus Belebtschlamm und Biofilmen in diesem Testverfahren erfolgreich eingesetzt und weitere Einflussparameter untersucht.
Wir suchen aktuell interessierte Studierende, die eine Studienarbeit, Bachelorarbeit und/oder Masterarbeit entweder im Gebiet Photochemie oder Biologie der Phosphonate anfertigen wollen. Wir freuen uns auch über Anfragen von Studierenden, die ein Forschungs- und/oder Praxissemester bei uns am Lehrstuhl absolvieren wollen. Auch Praktia oder wissenschaftliche Gastaufenthalte sind an unserem Lehrstuhl herzlich willkommen. Bei nährerem Interesse kontaktieren Sie bitte direkt unsere Ansprechpartner*innen.
Ansprechpartner*inn: Dr.-Ing. Ramona Riedel & Prof. Dr. Marion Martienssen
Film zu Phosphonaten
Reduzierung von Membran Biofouling durch Quorum Quenching
Membranbioreaktoren (MBR) sind seit vielen Jahren ein fester Bestandteil in der kommunalen sowie industriellen Abwasserreinigung. Durch die Platzersparnis und hohen Reinigungsleistungen, sind MBR in vielen Anwendungsbereichen kaum ersetzbar. In den letzten zwei Jahrzehnten wurde sehr viel im Bereich Membrantechnologie geforscht, um die Leistungsfähigkeit von MBR immer weiter zu optimieren und zu verbessern. Trotz allem ist eines der größten Probleme, Biofouling, in der MBR-Technik bisher nicht vollständig gelöst worden.
Aus neueren Studien geht hervor, dass Quorum Sensing (QS), Zell-Zell-Kommunikation, einen erheblichen Anteil zum Biofouling auf den Membranen hat. Frühzeitiges Unterbinden von Quorum Sensing durch Quroum Quenching (QQ) könnte somit zu einer wesentlichen Reduzierung von Biofouling führen. Ziel dieses Projektes ist durch sogenannte QQ-Techniken Biofouling auf den Membranen eines MBR nachweislich zu reduzieren. Dafür müssen ist optimalen Betriebsbedingungen hinsichtlich physikalischer (Reibung) und biologischer (Quorumlöschung) Parameter bestimmt werden. Dafür werden gezielt zwei Reinkulturen auf speziellen Trägermaterialien immobilisiert mit der MBR-Biomasse vergesellschaftet. Der Einfluss der beiden Reinkulturen wird mit Fouling-Experimenten überprüft. Bei erfolgreicher Etablierung von QQ könnte somit die Stand- und Lebenszeit der Membran nachhaltig verlängert und somit verbessert werden.
Im Rahmen diese Projektes wird aktuell am Lehrstuhl eine Doktorarbeit angefertigt.
Ansprechpartner: M.Sc. Noman Sohail & Prof. Dr. Marion Martienssen
Aufklärung von Abbaumechanismen ausgewählter PFAS mittels AOP
Der Einsatz von polyfluorierten Carbonsäuren/Sulfonsäuren (PFAS) ist trotz ihrer potenziellen Umweltgefährdung in einigen Industriezweigen unablässlich. So sind PFAS nach wie vor ideale Subtanzen für Feuerlöschmittel. Die Grundstruktur solcher Additive kann jedoch immer wieder auf Perfluorooctansäure (PFOA) oder Perfluorooctansulfonsäure (PFOS) zurückgeführt werden. Beide, PFOA und PFOS, gehören zu den klassischen PFAS, die unter Verdacht stehen persistent, bioakumulativ und gesundheitlich bedenklich zu sein. Die Produktion beider Grundstrukturen wurde bereits in Deutschland und der EU eingestellt. Alternative Strukturen mit denselben oder sehr ähnlichen chemischen Eigenschaften konnten PFOA und PFOS bisher nicht gänzlich subsituieren. Zudem ist auch über ihr Umweltverhalten nur wenig bekannt.
In diesem Projekt wird mit Hilfe innovativer APO-Verfahren wie UV-, nanokatalytische UV- und Ozonung der Abbau von neuartigen PFAS untersucht. Ziel ist es typische Abbaumechanismen mittels LC/MS-Analysen aufzuklären und den Einfluss von Strukturveränderungen auf den abiotischen Abbau zu untersuchen. Ferner werden auch sogenannter "partiel cracking"-Versuche zum potentiell vereinfachten biologischen Abbau untersucht.
Wir suchen aktuell interessierte Studierende, die eine Studienarbeit, Bachelorarbeit und/oder Masterarbeit in diesem Forschungsgebite anfertigen wollen. Wir freuen uns auch über Anfragen von Studierenden, die ein Forschungs- und/oder Praxissemester bei uns am Lehrstuhl absolvieren wollen. Auch Praktia oder wissenschaftliche Gastaufenthalte sind an unserem Lehrstuhl herzlich willkommen. Bei nährerem Interesse kontaktieren Sie bitte direkt unsere Ansprechpartner*innen.
Ansprechpartner: Dr.-Ing. Ramona Riedel & Prof. Dr. Martienssen
Solare Trinkwasserdesinfektion mit kombinierter AOP
Die Verfügbarkeit von frischem Trinkwasser ist vor allem in Entwicklungsländern eine tägliche Herausforderung für Millionen von Menschen. Noch immer sterben täglich Menschen durch Wassermangel oder Krankheiten ausgelöst durch fäkale Verunreinigungen. Aus diesem Grund sind möglichst einfache und kostengünstige Desinfektionsverfahren für viele Menschen essentiell. Hybride dezentrale Wasseraufbereitungstechnologie kombiniert mit erneuerbaren Energiequellen stellen einen nachhaltigen Ansatz für eine sichere Wasserversorgung mit einem gleichzeitig geringeren Stromverbrauch dar. Gerade für Entwicklungsländer und ländliche Gemeinden bietet die dezentrale Wasseraufbereitung mit Sonnenlicht eine kostengünstige, modulare und unkomplizierte Möglichkeit Wasser autark zur reinigen bzw. zu desinfizieren.
Ziel dieses Projektes ist es eine simple Technologie zur dezentralen Trinkwasserdesinfektion zu entwickeln. Dafür soll die Eignung und Implementierung unterschiedlicher photochemischer Oxidationsverfahren wie (UV)/TiO2 und UV/H2O2 für eine dezentrale Behandlungstechnologie für Entwicklungsländer untersucht werden. In einem weiteren Schritt ist die Nutzung von Sonnenlicht als Energiequelle für das neuartige Desinfektionsverfahren zu untersuchen und zu optimieren. Die Wasserqualität durch die Desinfektion wird in Anlehnung an standardisierte Testverfahren überprüft. Schließlich ist die Übertragbarkeit der Technologie nach Ghana zu ermitteln.
Im Rahmen diese Projektes wird aktuell am Lehrstuhl eine Doktorarbeit angefertigt.
Ansprechpartner: Abdul-Rahaman Afitiri & Prof. Dr. Martienssen
Schweinfurter Grün
Bei vielen Objekten des kulturellen Erbes, besonders zu Beginn des 19. Jahrhunderts, wurde vermehrt auf Farbmischungen, wie das Schweinfurter Grün zurückgegriffen, die gefährliche arsenhaltige Verbindungen in Form von Staub und Gasen freisetzen. Die Bewertung einer möglichen Gefährdung gestaltet sich jedoch besonders kompliziert. Aus diesem Grund ist das Ziel dieses Projekts "ART-Test" (Arsen Related Toxicity -Test) die Entwicklung einer integralen, pigmentübergreifenden und effektiven Methodik für die Identifizierung des Gefährdungspotentials, das durch flüchtige Arsenverbindungen von mit Schweinfurter Grün belasteten, historischen Objekten ausgeht. Hierbei wird auch auf die mögliche Gefährdung von freigesetzten Arsenverbindungen durch beteiligte Mikroorganismen (Pilze und Bakterien) eingegangen. Trotz der Vielzahl an möglichen Farbpigmenten und potenziell freigesetzten Arsenverbindungen sowie der häufig nur im Spurenbereich vorkommenden Belastung (< 1 ng/m³) soll mit dem neuen Verfahren eine schnelle Auswertung der konkreten Gefährdung für bestimmte Personengruppen (Restauratoren, Mitarbeiter in Museen, Besucher, Bewohner von Altbauten etc.) ermittelt werden.
Wir suchen aktuell interessierte Studierende, die eine Studienarbeit, Bachelorarbeit und/oder Masterarbeit im Bereich Genomeditierung an Pilzen oder zur Entwicklung eines molekularbiologischen Testverfahrens anfertigen wollen. Wir freuen uns auch über Anfragen von Studierenden, die ein Forschungs- und/oder Praxissemester bei uns am Lehrstuhl absolvieren wollen. Auch Praktia oder wissenschaftliche Gastaufenthalte sind an unserem Lehrstuhl herzlich willkommen. Der Arbeitsort wäre für dieses Projekt Senftenberg. Bei nährerem Interesse kontaktieren Sie bitte direkt unsere Ansprechpartner*innen:
Ansprechpartner*innen: M.Sc. Victoria Liedtke & Prof. Dr. Marion Martienssen